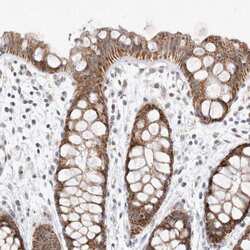

Antibody data
- Antibody Data
- Antigen structure
- References [0]
- Comments [0]
- Validations
- Western blot [1]
- Immunohistochemistry [8]
Submit
Validation data
Reference
Comment
Report error
- Product number
- PA5-55258 - Provider product page

- Provider
- Invitrogen Antibodies
- Product name
- MRPL37 Polyclonal Antibody
- Antibody type
- Polyclonal
- Antigen
- Recombinant protein fragment
- Description
- Immunogen sequence: TDGRVFHFLV FQLNTTDLDS NEGVKNLAWV DSDQLLYQHF WCLPVIKKRV VVEPVGPVGF KPETFRKFLA LYLHGA Highest antigen sequence identity to the following orthologs: Mouse - 84%, Rat - 86%.
- Reactivity
- Human
- Host
- Rabbit
- Isotype
- IgG
- Vial size
- 100 μL
- Concentration
- 0.1 mg/mL
- Storage
- Store at 4°C short term. For long term storage, store at -20°C, avoiding freeze/thaw cycles.
No comments: Submit comment
Supportive validation
- Submitted by
- Invitrogen Antibodies (provider)
- Main image

- Experimental details
- Western blot analysis of MRPL37 using MRPL37 Polyclonal Antibody (Product # PA5-55258) (A) shows similar pattern to an independent MRPL37 Polyclonal Antibody (B).
Supportive validation
- Submitted by
- Invitrogen Antibodies (provider)
- Main image

- Experimental details
- Immunohistochemical staining of MRPL37 in human rectum using MRPL37 Polyclonal Antibody (Product # PA5-55258) shows moderate granular cytoplasmic positivity in glandular cells.
- Submitted by
- Invitrogen Antibodies (provider)
- Main image

- Experimental details
- Immunohistochemical staining of MRPL37 in human kidney using MRPL37 Polyclonal Antibody (Product # PA5-55258) shows moderate granular cytoplasmic positivity in cells in tubules.
- Submitted by
- Invitrogen Antibodies (provider)
- Main image

- Experimental details
- Immunohistochemical staining of MRPL37 in human endometrium using MRPL37 Polyclonal Antibody (Product # PA5-55258) shows weak cytoplasmic positivity in glandular cells.
- Submitted by
- Invitrogen Antibodies (provider)
- Main image

- Experimental details
- Immunohistochemical staining of MRPL37 in human pancreas using MRPL37 Polyclonal Antibody (Product # PA5-55258) shows weak granular cytoplasmic positivity in exocrine glandular cells.
- Submitted by
- Invitrogen Antibodies (provider)
- Main image
- Experimental details
- Immunohistochemical staining of MRPL37 in human rectum using MRPL37 Polyclonal Antibody (Product # PA5-55258) shows moderate granular cytoplasmic positivity in glandular cells.
- Submitted by
- Invitrogen Antibodies (provider)
- Main image

- Experimental details
- Immunohistochemical staining of MRPL37 in human kidney using MRPL37 Polyclonal Antibody (Product # PA5-55258) shows moderate granular cytoplasmic positivity in cells in tubules.
- Submitted by
- Invitrogen Antibodies (provider)
- Main image

- Experimental details
- Immunohistochemical staining of MRPL37 in human endometrium using MRPL37 Polyclonal Antibody (Product # PA5-55258) shows weak cytoplasmic positivity in glandular cells.
- Submitted by
- Invitrogen Antibodies (provider)
- Main image

- Experimental details
- Immunohistochemical staining of MRPL37 in human pancreas using MRPL37 Polyclonal Antibody (Product # PA5-55258) shows weak granular cytoplasmic positivity in exocrine glandular cells.
 Explore
Explore Validate
Validate Learn
Learn Western blot
Western blot